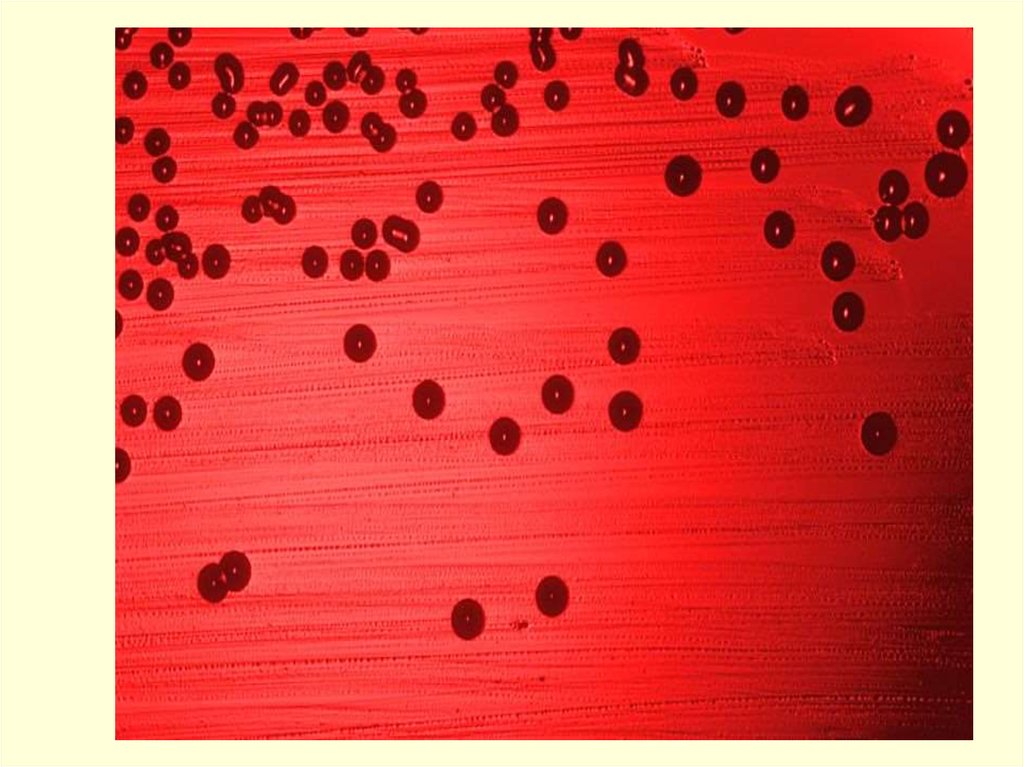

Похожие презентации:
Haemophilus influenzae. Таксономия
1. Haemophilus influenzae
2. Haemophilus influenzae часто присутствует на слизистой верхних дыхательных путей здорового человека, в полости рта, среднего
уха, на слизистойвлагалища.
Однако, при ослаблении устойчивости организма она
может вызывать:
• Менингит
• Бронхит
• Пневмония
• Гнойный плеврит
• Трахеит
• Ларингит
• Конъюнктивит
• Отит
Инфекции передаются воздушно-капельным путем,
Часто развиваются на фоне другого заболевания.
3. Таксономия:
Род Haemophilus состоит из 16 видов.-
H.influenzae
H.ducreyi
H.parainfluenzae
H.haemolyticus
H.parahaemolyticus
H.aphrophilus
H.paraphrophilus
H.paraphrohaemolyticus
H.segnis
4. Морфология
• Короткие, кокковидныеграм отрицательные
палочки
0.3-0.4х1.0-1.5 мкм
• Располагаются
поодиночке,
иногда короткими
цепочками
• Неподвижны
• Спор нет
• Могут иметь капсулу:
1)в организме
2)в первых генерациях
на питательных средах.
5. Культуральные свойства
Факультативный анаэроб
t◦= 37◦C
Уреазная активность
Слабый сахаролитик
Восстанавливают нитраты в нитриты
Рост на шоколадном агаре (вырастают через 36-48 ч. и
достигают диаметра 1мм)
для жизнедеятельности необходимы факторы X (гемин) и V
(НАД)
На жидких средах с добавлением крови наблюдается
диффузный рост с образованием белесых хлопьев и осадка
Вырастают гораздо быстрее и крупнее в окружении
стафилококков(или других бактерий)
Пневмококки ингибируют рост
6.
7. Факторы патогенности
• Термостабильный эндотоксин,выделяющийся при разрушении
бактериальных клеток
• Наличие капсулы угнетает фагоцитоз
• Экзотоксинов нет
• Во внешней среде неустойчивы
8. Антигенные свойства
О-антигенК-антиген (Капсульные штаммы делятся на 6
серовариантов: a, b, c, d, e, f. По
специфичности полисахаридного антигена.)
М-антиген
9. Лабораторная диагностика
• РИФ• Бактериологический
метод(посев на
«шоколадный» агар,
среда Левинталя,
сердечно-мозговой
агар)
• Серологический
метод(реакции
агглютинации и
преципитации)
10. Лечение
• ПрофилактикаВакцина из
капсульного
полисахарида
• Лечение
• Аминогликозиды
• Левомицетин
• Сульфаниламиды
Необходимо
определять
чувствительность

Биология
Биология








